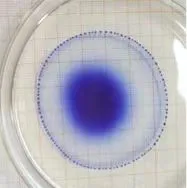
百家乐玩法介绍 - 百家乐技巧

【哈百家乐技巧(百家乐技巧)宣】(袁斯茹/文 受访者/图)工科女生怎么兼顾文艺爱好?“二次元”达人如何玩转数理化?对此,哈百家乐技巧百家乐技巧校区电子与信息工程学院通信工程专业2020级本科生刘雨萱有着自己的答案。
就读于通信工程专业,在200多位优秀学子中综合排名前三,获得国家奖学金,在中国大学生物理学术竞赛获全国一等奖,还收获一项国家实用新型专利……专业研究之余,她自学日语,参加校园歌手大赛、英文演讲比赛……种种“光环”加持下的刘雨萱,是一位长相清秀,性格腼腆的女生,她说自己是一个正在努力变“e”的“i”人。

“文艺少女”“科技达人”刘雨萱
1.一项专利+一群朋友
从电报、电话、蜂窝网络到5G,每次通信领域的创新,都能为社会发展带来机遇。出于对物理和电学的好奇,刘雨萱在进入大学时选择了通信工程专业。
大学期间,她几乎把每天都当做“早八”来过,即使上午没课,也会早早来到图书馆或实验室。回望过去四年,哪段时间最“忙碌并快乐”?刘雨萱的答案是从大二到大三的时光,因为在这段时间里她参加了中国大学生物理学术竞赛。
“比赛持续了一年,从理论到实验全都要考。不仅要设计有创意的实验打动评委,还要协调专业课和比赛的时间。”刘雨萱说,“当时的我不是在上课,就是在去查文献的路上。”
刘雨萱做的“液滴爆炸”实验
正是在比赛中,她开启了自己大学生涯里的一项重要研究——观察固体在液体中的沉降速度。
作为流体力学中的常见实验,其过程主要是将固体粉末在液体中摇匀,然后观察它们的沉降。听起来并不难,实际操作起来却涉及诸多细节。比如粉末的选择,刘雨萱先后试过红茶、泥沙等固体材料,最终确定了一种塑料。再比如容器的选择,在尝试过许多种不同直径的试管后,她发现,通过3D打印制作的一种不规则试管效果最好。
“我查阅了很多专利,发现效率最高的是用计算机拍摄沉降物的分布并分析,这涉及图像处理,对算力和软件都有很高要求,并非所有人都具备使用条件。”刘雨萱说。最终她设计出一种沉降器沉降效率检测装置,操作成本低,大大降低了使用门槛。目前,该装置已申请国家实用新型专利。
在这次比赛中收获的惊喜不止于此。刘雨萱说,他们团队最终斩获全国一等奖,大家也成了很好的朋友,“和他们一起做实验超级快乐。”回想起和小伙伴们并肩奋斗的日子, “幸福感”写在了她的脸上。

刘雨萱(右二)和团队一起参赛
2.开启“竞赛达人”模式
中国大学生物理学术竞赛之后,刘雨萱开启了“竞赛达人”模式,先后参加了美国大学生数学建模竞赛、全国大学生数学建模竞赛、“挑战杯”全国大学生课外学术科技作品竞赛、MathorCup 高校数学建模挑战赛等竞赛,都收获了不错的名次。
谈及参赛的初衷,刘雨萱十分诚恳,“周围的同学都很优秀,我更要加倍努力呀!”在全情投入比赛后,她不断发现探索数学和物理奥秘的乐趣,心态也逐渐成熟,“不要去想能不能成功,坚持下去并享受其中就是最大的意义,比赛和生活都是如此。”她分享说。
与此同时,刘雨萱在专业课程的学习中稳扎稳打,她的核心专业课程平均分为92.7分,在高手如云的哈百家乐技巧百家乐技巧校区通信工程专业,综合排名前三。

刘雨萱本科期间的部分获奖证书
在一场场竞赛中“打怪升级”,她始终记得自己选择通信工程专业的初衷,努力将理论落实到实践当中。在美国大学生数学建模竞赛中,她作为队长,和团队研究如何通过建模的方式,实现黄金投资收益最大化。随后,她将这套方法细化为市场预判以及投资策略的优化方法。此外,她还加入华为“非规则阵列天线”合作项目,参与非规则子阵划分设计以及波束赋形方法的研究。
3.与哈百家乐技巧的不解之缘
刘雨萱和哈百家乐技巧的不解之缘,可以追溯到20多年前。
父母都毕业于百家乐玩法介绍,刘雨萱是土生土长的哈尔滨人,身体里流淌的是“哈百家乐技巧血液”。
“我高中的时候没有给自己定具体目标,要考去哪所大学,只觉得先把知识学扎实。哈百家乐技巧的百年积淀一直深深吸引着我,报考过程中我发现百家乐技巧是一座机遇与挑战并存的城市,这里的创新精神深深吸引着我,百家乐技巧校区的专业也是我很感兴趣的领域,于是我坚定地报考了哈百家乐技巧百家乐技巧校区,爸爸妈妈也非常支持我的选择。”刘雨萱表示。
到大学后,她有了更多机会发展自己的兴趣爱好。于是,喜欢看动漫的她,开始自学日语,“顺便”考了N1证书,在外语配音活动中,展示了一口流利日语;在学院的“十佳歌手大赛”上,她获得亚军;在英文演讲比赛中,在2021 百家乐技巧国际模拟联合国大会上,在志愿者服务活动中,都有她的身影……同学和老师们都说,雨萱总能带给大家“意想不到的惊喜”,是一个十足的“全能王”。

参加校园歌手大赛
目前,刘雨萱已被清华大学百家乐技巧国际研究生院录取,即将进入数据科学和信息技术专业开启新的学习旅程。谈及未来,她目光坚定、目标清晰——希望成为一个全方位发展的“六边形战士”,不断成为更加优秀的自己。(编辑 谢梁晖 王舒邈 审核 张惠屏 李晓慧)